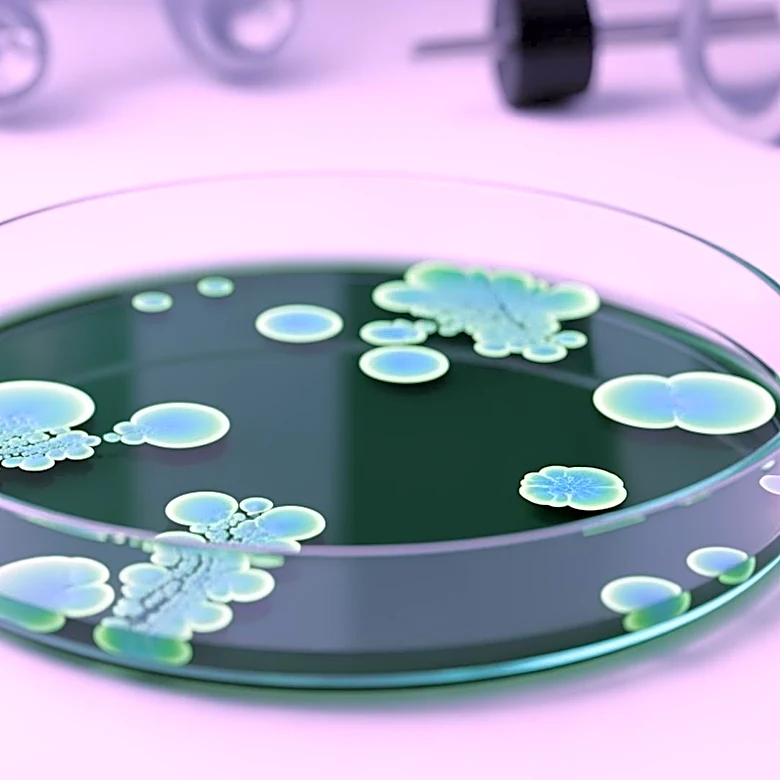
Study Reveals Antiseptic Tolerance in Hospital Bacteria, Raising Concerns Over Antibiotic Resistance

What's Happening?
A study from the University of California, Riverside, published in PNAS Nexus, challenges the traditional view that Alzheimer's disease is primarily caused by amyloid plaques. The research suggests that the disease may result from a competition between
amyloid beta (a-beta) and tau proteins within neurons. The study found that a-beta and tau compete for binding sites on microtubules, essential structures for cellular transport. This competition could displace tau, disrupting cellular functions and potentially leading to Alzheimer's symptoms. The findings propose that the buildup of these proteins might be a consequence rather than the cause of the disease, offering a new perspective on Alzheimer's pathology.
Why It's Important?
This study is significant as it could reshape the understanding of Alzheimer's disease, which affects millions worldwide. By suggesting that protein competition, rather than plaque buildup, may be central to the disease, the research opens new avenues for treatment strategies. Current therapies focusing on plaque removal have largely been unsuccessful, and this new approach could lead to more effective interventions. Understanding the interplay between a-beta and tau could also help identify early biomarkers for the disease, improving diagnosis and management.
What's Next?
The findings call for a reevaluation of Alzheimer's research priorities, potentially shifting focus from plaque removal to strategies that prevent protein competition. Future studies may explore ways to stabilize microtubules or enhance the brain's protein clearance systems. These insights could lead to the development of novel therapies aimed at preserving neuronal function and slowing disease progression. The research community may also investigate the role of other proteins in Alzheimer's, further broadening the understanding of its complex pathology.